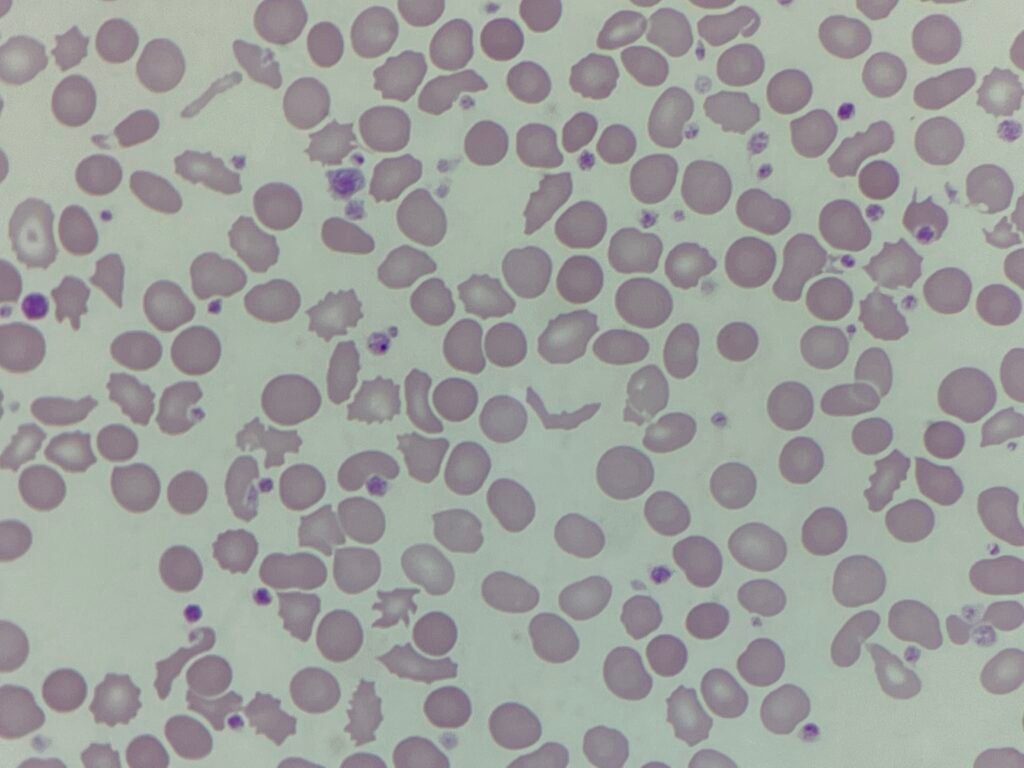
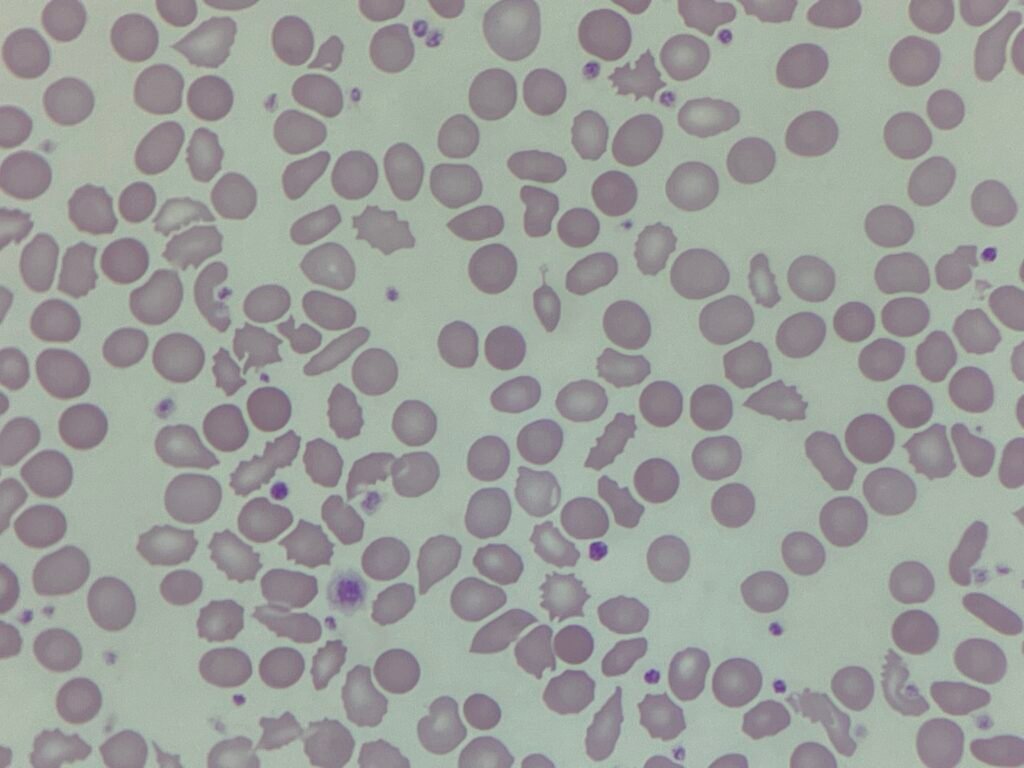
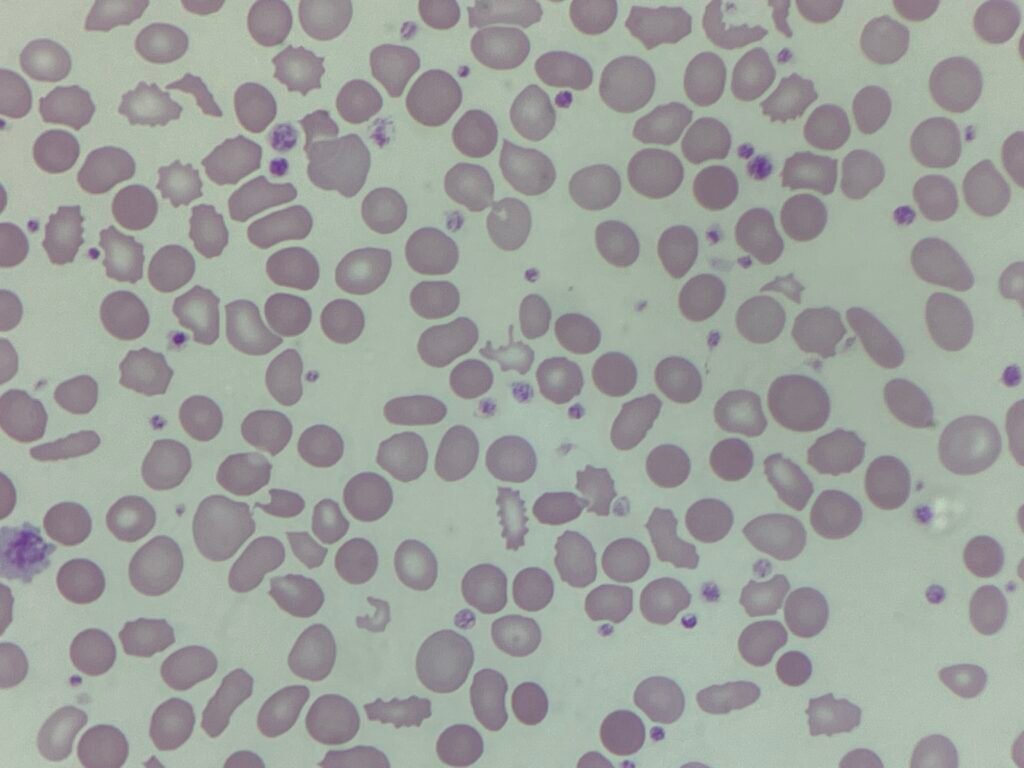
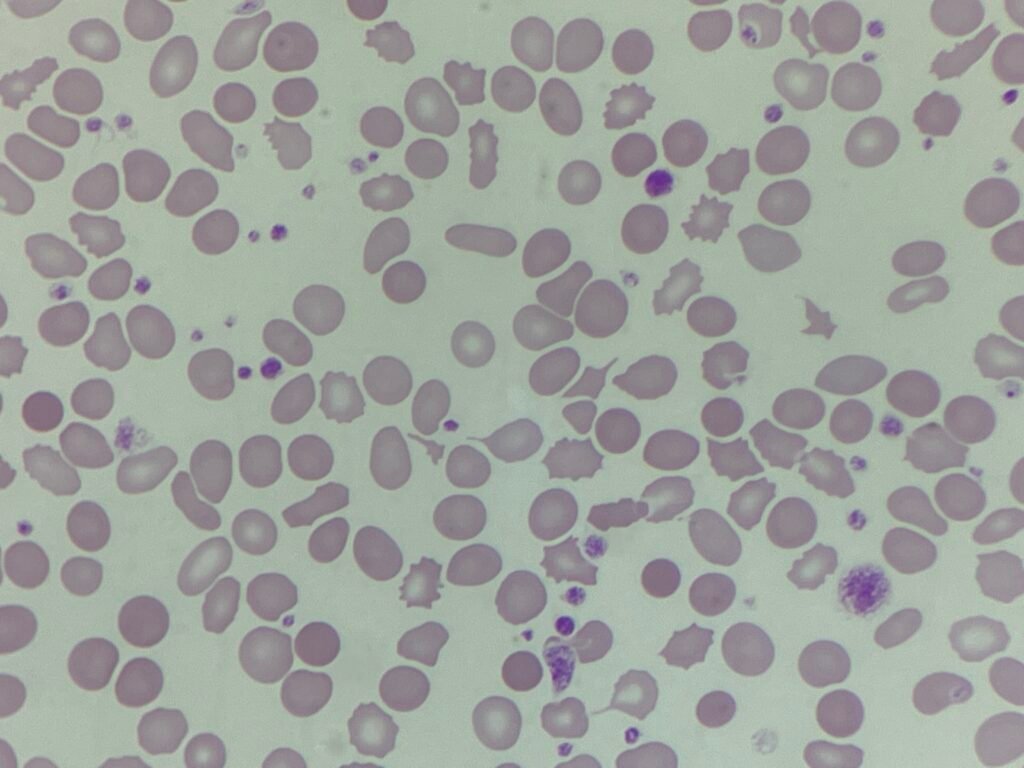
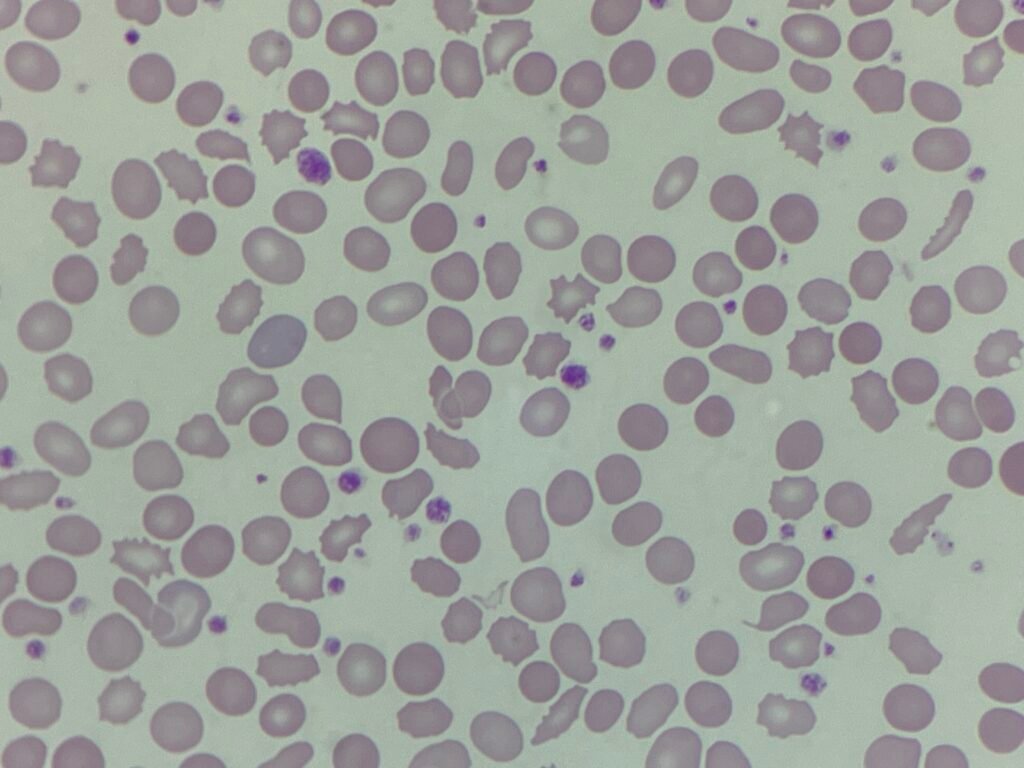
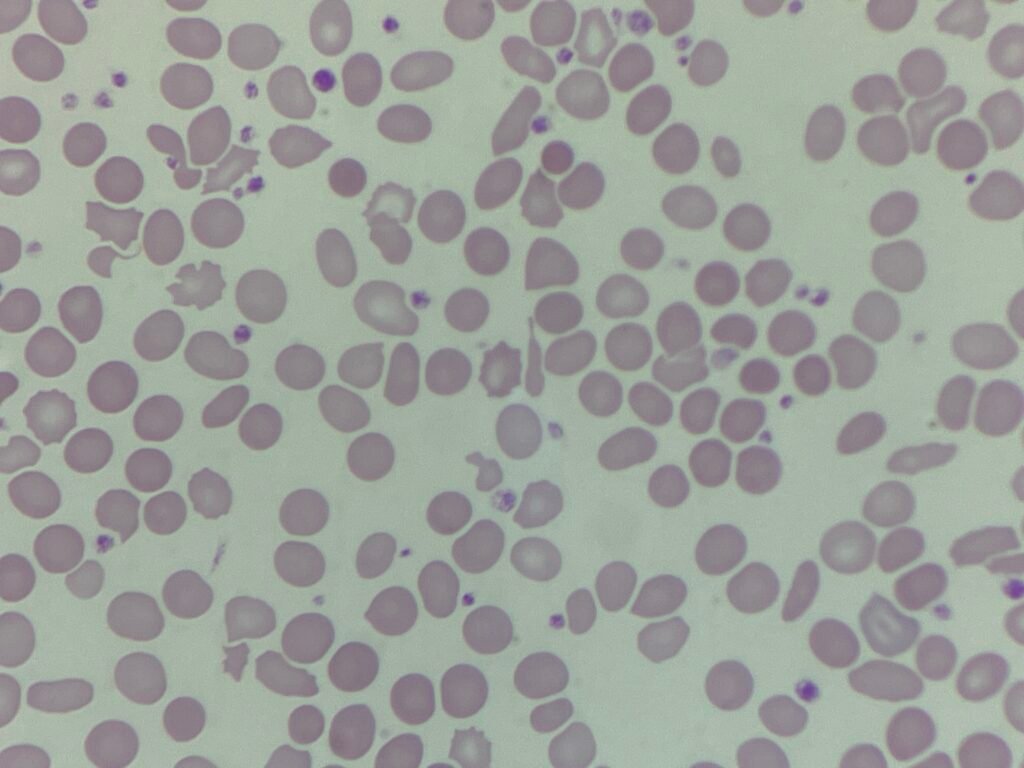

This week’s case comes from a patient with a complex clinical background. The patient presented with anaemia and a raised platelet count, alongside signs of systemic illness. Blood results included:
- Hb: 106 g/L
- MCV: 83.7 fL
- MCH: 25.4 pg
- Platelets: 740 ×10⁹/L
- WBC: 25.4 ×10⁹/L
The blood film reveals some striking images.

What significant features can you see on the blood film images, and what do you think it could be?
As always, the summary of the case will be shared at the end of the week! Feel free to follow along with the case on LinkedIn at the Only Cells page or on the Only Cells Twitter page.
2 Comments
Upon discussing with colleagues, we have noted the following red cell features
– elliptocytes and acanthocytes
– platelet anisocytosis
– mild polychromasia
– burr cells
– schistocytes
– spherocytes
It could be a possible haemoglobinopathy, a response to chronic bleeding or haemolysis, or a membrane abnormality.
We feel we we would need more clinical details and patient demographics, biochemistry test results to aid diagnosis.
Yes, you’ve identified the most important features. And you’re right, without further information it would be difficult to discern the cause exactly.